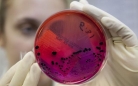

В инфекционной больнице Карагандинской области скончались двое из пяти человек, госпитализированных с подозрением на сибирскую язву, передает корреспондент Today.kz со ссылкой на источник в областной инфекционной больнице.
"Два человека скончались. Причина их смерти будет установлена экспертами. К нам они поступили с подозрением на сибирскую язву. Трое других пациентов остаются в условиях реанимации, - сообщили в областной инфекционной больнице. - Результатов лабораторных исследований о диагнозе пока нет".
Все пятеро - жители села Еркиндик Шетского района. Предположительно, они могли заразиться болезнью от животных, поскольку все пятеро перед заболеванием резали скот.
Напомним, пятеро жителей Шетского района в возрасте от 24 до 50 лет поступили в областную инфекционную больницу в ночь на 20 июня. Врачи подозревают у них сибирскую язву, но эксперты пока не выявили в их организмах возбудителя этого опасного заболевания.
После забоя скота в районную больницу с жалобой на температуру обратились и двое жителей ВКО. У мужчин также подозревают сибирскую язву. Результаты лабораторных исследований будут известны 27 июня.